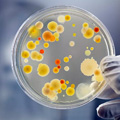
安利

產品應用
PRODUCT APPLICATION
全部分類
工程裝飾
高 品 質 工 程 裝 飾 用 聚 氨 酯 復 合 材 料

視覺感:
真皮感強或新穎時尚的織物風格;
手感質感佳:
柔軟豐滿,觸感好,回彈性優越;
真皮感強或新穎時尚的織物風格;
手感質感佳:
柔軟豐滿,觸感好,回彈性優越;

物理性能卓越:
— 撕裂強度好、縫合強度好;
— 表面耐磨、耐刮性佳;
— 耐光性好,耐老化性能好;
— 色牢度好,不易掉色,防汗漬,色澤穩定性好,耐黃變好;
— 耐化學性能好,耐溶劑性能好;
— 撕裂強度好、縫合強度好;
— 表面耐磨、耐刮性佳;
— 耐光性好,耐老化性能好;
— 色牢度好,不易掉色,防汗漬,色澤穩定性好,耐黃變好;
— 耐化學性能好,耐溶劑性能好;

耐久性:
產品可具有良好的耐用性和耐酸、耐堿、耐水解性,使用時間長。根據客戶要求,經安利確認,產品可達5~20年耐用性能;
產品可具有良好的耐用性和耐酸、耐堿、耐水解性,使用時間長。根據客戶要求,經安利確認,產品可達5~20年耐用性能;



超強的去污功能:
生活中經常會出現茶水、牛奶、咖啡、油污、圓珠筆印等污漬,難以清洗 。根據客戶要求,經安利確認,產品可提供超易去污功能,具有防污、易去污 、易清洗的特別性能,可以將污漬輕松擦去,易于清洗和保養;
生活中經常會出現茶水、牛奶、咖啡、油污、圓珠筆印等污漬,難以清洗 。根據客戶要求,經安利確認,產品可提供超易去污功能,具有防污、易去污 、易清洗的特別性能,可以將污漬輕松擦去,易于清洗和保養;

超強的阻燃性:
根據客戶要求,經安利確認,產品可達到BS5852、USA.CA117、FMVSS302等國際阻燃標準,提供使用者更加優異的阻燃保障,更加安全;
根據客戶要求,經安利確認,產品可達到BS5852、USA.CA117、FMVSS302等國際阻燃標準,提供使用者更加優異的阻燃保障,更加安全;
超強的抗菌功能:
根據客戶要求,經安利確認 , 產品具有抑制材料表面細菌、霉菌侵入和繁殖的功能,可以達到ISO22196-2011和ASTM G21-2009國際抗菌 、防霉標準,有利于人體健康 、衛生和舒適,提高消費者的生活和健康水平;
根據客戶要求,經安利確認 , 產品具有抑制材料表面細菌、霉菌侵入和繁殖的功能,可以達到ISO22196-2011和ASTM G21-2009國際抗菌 、防霉標準,有利于人體健康 、衛生和舒適,提高消費者的生活和健康水平;

環保性能卓越:
不含有機錫、重金屬、偶氮、多環芳烴等,可不含PFCs,DMF含量低,可達到小于5PPM限量要求。通過ISO14001環保管理體系、ISO14024(中國環境標志I型產品)。根據客戶要求,經安利確認,產品可達到REACH、ROHS、EN-71-3、DIN38407(ISO17353)、EN14362(AZO)、DIN53315、DIN53314(EN ISO17075)、EN 2006 122 EC(PFOS)、EN 2005 69 EC(PAHS)等環保要求。
不含有機錫、重金屬、偶氮、多環芳烴等,可不含PFCs,DMF含量低,可達到小于5PPM限量要求。通過ISO14001環保管理體系、ISO14024(中國環境標志I型產品)。根據客戶要求,經安利確認,產品可達到REACH、ROHS、EN-71-3、DIN38407(ISO17353)、EN14362(AZO)、DIN53315、DIN53314(EN ISO17075)、EN 2006 122 EC(PFOS)、EN 2005 69 EC(PAHS)等環保要求。

優良的產品質量:
安利管理先進,檢測設備齊全,實行ISO9001全面質量管理體系,產品質量優良。
安利管理先進,檢測設備齊全,實行ISO9001全面質量管理體系,產品質量優良。

敏捷快速的交貨保障:
安利技術先進,產能充足,生產管理卓越,效率高,產品交貨速度快,持續供貨能力強。
安利技術先進,產能充足,生產管理卓越,效率高,產品交貨速度快,持續供貨能力強。
安 利 產 品 應 用

凱賓斯基酒店內裝飾

美國小布什總統圖書館室內裝飾

卡塔爾多哈七星級火炬酒店內裝飾
網站導航(點擊進入)
CONTACT
聯系我們
電話:+0551-68992815 68991746 65896888
傳真:+0551-63858888 68991640
郵箱:algf@anli.cn anligroup@126.com
地址:中國安徽省合肥市經濟技術開發區桃花工業園拓展區(繁華大道與創新大道交叉口)


皖公網安備34012302000449號